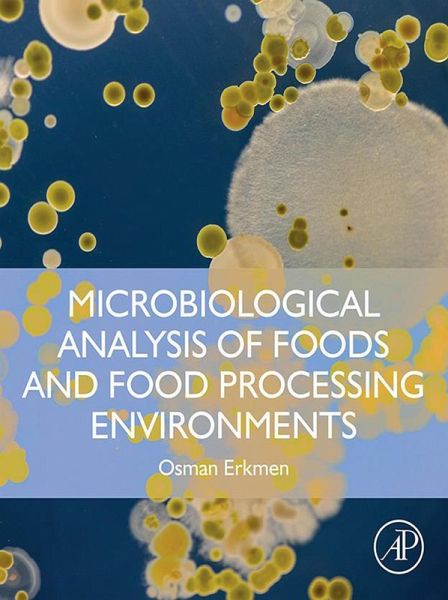
Microbiological Analysis of Foods and Food Processing Environments (eBook, ePUB)

Microbiological Analysis of Foods and Food Processing Environments (eBook, ePUB)
				PAYBACK Punkte
				
64 °P sammeln!
				Microbiological Analysis of Foods and Food Processing Environments is a well-rounded text that focuses on food microbiology laboratory applications. The book provides detailed steps and effective visual representations with microbial morphology that are designed to be easily understood. Sections discuss the importance of the characteristics of microorganisms in isolation and enumeration of microorganisms. Users will learn more about the characteristics of microorganisms in medicine, the food industry, analysis laboratories, the protection of foods against microbial hazards, and the problems an...
Microbiological Analysis of Foods and Food Processing Environments is a well-rounded text that focuses on food microbiology laboratory applications. The book provides detailed steps and effective visual representations with microbial morphology that are designed to be easily understood. Sections discuss the importance of the characteristics of microorganisms in isolation and enumeration of microorganisms. Users will learn more about the characteristics of microorganisms in medicine, the food industry, analysis laboratories, the protection of foods against microbial hazards, and the problems and solutions in medicine and the food industry. Food safety, applications of food standards, and identification of microorganisms in a variety of environments depend on the awareness of microorganisms in their sources, making this book useful for many industry professionals. - Includes basic microbiological methods used in the counting of microbial groups from foods and other samples - Covers the indicators of pathogenic and spoilage microorganisms from foods and other samples - Incorporates identification of isolated microorganisms using basic techniques - Provides expressed isolation, counting and typing of viruses and bacteriophages - Explores the detection of microbiological quality in foods
    Dieser Download kann aus rechtlichen Gründen nur mit Rechnungsadresse in A, B, BG, CY, CZ, D, DK, EW, E, FIN, F, GR, HR, H, IRL, I, LT, L, LR, M, NL, PL, P, R, S, SLO, SK ausgeliefert werden.